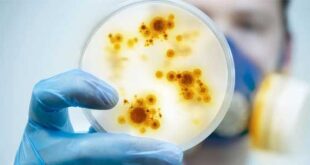

Έως τις 7 Ιουνίου είχαν καταγραφεί, παγκοσμίως, 1.088 επιβεβαιωμένα κρούσματα της ευλογιάς των πιθήκων σε 29 χώρες, σύμφωνα με τα Κέντρα Ελέγχου και Πρόληψης Νόσων (CDC) των ΗΠΑ. Τα περισσότερα από αυτά έχουν βρεθεί, κατά σειρά, στη Βρετανία (302), στην Ισπανία (198), στην Πορτογαλία (166), στον Καναδά (80), στη Γερμανία (80), στη Γαλλία (66), στην Ολλανδία (54), στις ΗΠΑ (34), …
Περισσότερα »Tag Archives: ευλογιά των πιθήκων
ΕΟΔΥ: Τα λοιμώδη νοσήματα δεν γνωρίζουν σύνορα και δεν κάνουν διακρίσεις στη μετάδοσή τους
Με αφορμή τη δημόσια συζήτηση που εξελίσσεται γύρω από την ευλογιά των πιθήκων, ο ΕΟΔΥ κρίνει σκόπιμο να επισημάνει ότι ο στιγματισμός πολιτών ή συμπεριφορών δεν προάγει τη δημόσια υγεία, αλλά αντίθετα στιγματίζει συγκεκριμένες κοινωνικές ομάδες, οδηγώντας σε εφησυχασμό άλλες ομάδες πολιτών, με συνέπεια να αυξάνεται ο κίνδυνος για τη διασπορά λοιμωδών νοσημάτων. Η ευλογιά των πιθήκων μπορεί να προσβάλει …
Περισσότερα »Αντιικό φάρμακο κατά της ευλογιάς πιθανόν να έχει αποτέλεσμα και κατά της ευλογιάς των πιθήκων
Ένα αντιικό φάρμακο που είχε αναπτυχθεί κατά της ευλογιάς, το tecovirimat, πιθανόν να μπορεί να βοηθήσει και κατά της ευλογιάς των πιθήκων, όπως δείχνει η πρώτη χρήση του που είχε γίνει στη Βρετανία, σε ασθενείς που είχαν διαγνωστεί με τη νόσο μεταξύ 2018-2021. Όμως τα ευρήματα κρίνονται ανεπαρκή, λόγω του μικρού αριθμού των ασθενών. Απαιτείται περαιτέρω έρευνα. Το φάρμακο, που …
Περισσότερα »Πλεύρης: «Δεν τίθεται θέμα μαζικού εμβολιασμού για την ευλογιά των πιθήκων»
Στην ευλογιά των πιθήκων και στα δεδομένα που ισχύουν για τη χώρα μας, καθώς και στον θεσμό του προσωπικού ιατρού που αναμένεται να εφαρμοστεί άμεσα αναφέρθηκε ο Υπουργός Υγείας, Θάνος Πλεύρης, μιλώντας το πρωί στον ΑΝΤ1 και στην εκπομπή «Καλημέρα Ελλάδα». • Ως προς την Ευλογιά των Πιθήκων Η μεταδοτικότητα, μέχρι στιγμής, με τα δεδομένα, είναι σχετικά χαμηλή, καθώς απαιτείται …
Περισσότερα »Εθνική Επιτροπή Εμβολιασμών: Πολύ μικρός ο κίνδυνος από την ευλογιά των πιθήκων για τον γενικό πληθυσμό στη χώρα μας
Η Εθνική Επιτροπή Εμβολιασμών (ΕΕΕ), στη σημερινή συνεδρίασή της, εξέτασε τα υπάρχοντα επιστημονικά και επιδημιολογικά δεδομένα αναφορικά με την εμφάνιση κρουσμάτων ευλογιάς των πιθήκων (monkeypox). H ευλογιά των πιθήκων είναι σπάνια ιογενής εξανθηματική νόσος. Μεταδίδεται από άγρια ζώα (κυρίως τρωκτικά) που βρίσκονται σε περιοχές της Κεντρικής και Δυτικής Αφρικής. Σπανίως η μετάδοση της νόσου γίνεται από άνθρωπο σε άνθρωπο μέσω …
Περισσότερα »Ευλογιά των πιθήκων (monkeypox): Καθηγητές του ΕΚΠΑ συνοψίζουν τα μέχρι στιγμής δεδομένα
Πριν από δύο εβδομάδες, μία επιδημική έξαρση κρουσμάτων ευλογιάς των πιθήκων ανιχνεύθηκε για πρώτη φορά στο Ηνωμένο Βασίλειο, προκαλώντας ανησυχία στους ειδικούς δημόσιας υγείας. Οι ιατροί της Θεραπευτικής Κλινικής και της Ιατρικής Σχολής του Εθνικού και Καποδιστριακού Πανεπιστημίου Αθηνών Γιάννα Ρέντζιου (Παθολόγος-Λοιμωξιολόγος), Θεοδώρα Ψαλτοπούλου (Καθηγήτρια), Μαρία Καντζανού (Αναπληρώτρια Καθηγήτρια), Γιάννης Ντάνασης, Ροδάνθη Ελένη Συρίγου, Πάνος Μαλανδράκης, Δημήτρης Παρασκευής (Αναπληρωτής Καθηγητής …
Περισσότερα »Ευλογιά των πιθήκων: Πώς μεταδίδεται, ποια τα συμπτώματα, τι πρέπει να κάνουμε
Αυξάνονται διεθνώς τόσο τα επιβεβαιωμένα όσο και τα ύποπτα κρούσματα ευλογιάς των πιθήκων ή πιο σωστά των μαϊμούδων (monkeypox). Πολλά από αυτά είναι άγνωστης προέλευσης, πράγμα που σημαίνει ότι ο ιός που την προκαλεί, πιθανώς εξαπλώνεται κάτω από το “ραντάρ” των υγειονομικών αρχών. Στη χώρα μας, μέχρι στιγμής, δεν έχει καταγραφεί κάποιο ύποπτο κρούσμα ευλογιάς των πιθήκων, σύμφωνα με ανακοίνωση …
Περισσότερα » Health Update Health Update
Health Update Health Update